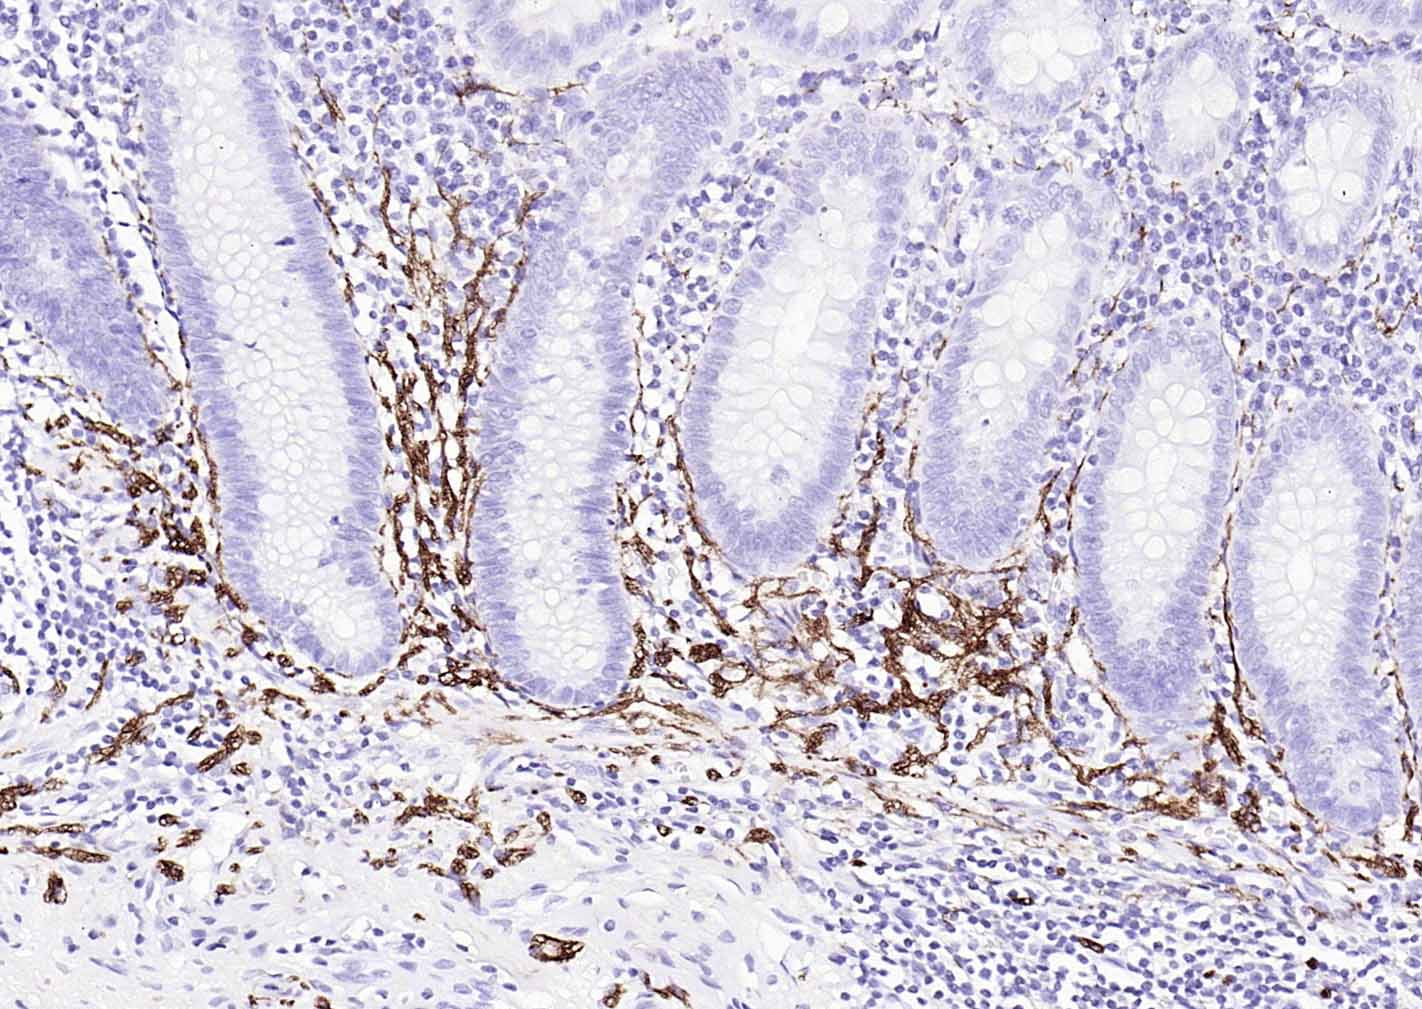
NCAM/CD56 Recombinant Mouse mAb (一抗) - IHC-P,IHC-F,IF | Bioss

NCAM/CD56 Recombinant Mouse mAb (一抗) - IHC-P,IHC-F,IF | Bioss

概述
细胞粘附蛋白(Call Adhesion Protein) 神经元标志物 NCAM-1为神经细胞粘附分子,主要分布于神经组织,神经—肌肉接头,神经—内分泌腺和某些内分泌腺以及大多数神经外胚层来源的细胞、组织和肿瘤中。 NCAM 1主要用于视网膜母细胞瘤、髓母细胞瘤、星形细胞瘤、神经母细胞瘤等肿瘤方面的研究。CD56(神经细胞黏附分子,NCAM)表达于大部分神经外胚层来源的细胞系、组织和肿瘤如视网膜母细胞瘤、成神经管细胞瘤、星形细胞瘤以及成神经细胞瘤。它也表达于一些中胚层来源的肿瘤如横纹肌肉瘤。NK细胞以及NK细胞淋巴瘤为阳性。CD56被认为是NK细胞肿瘤的重要标志物。该抗体识别分子量为180,145和125kDa亚型。
This gene encodes a cell adhesion protein which is a member of the immunoglobulin superfamily. The encoded protein is involved in cell-to-cell interactions as well as cell-matrix interactions during development and differentiation. The encoded protein has been shown to be involved in development of the nervous system, and for cells involved in the expansion of T cells and dendritic cells which play an important role in immune surveillance. Alternative splicing results in multiple transcript variants. [provided by RefSeq, Jun 2011]

产品应用
| 应用 | 已检合格种属 | 预测种属 | 推荐稀释比例 |
|---|---|---|---|
| IHC-P | Human | 1:100-500 | |
| IHC-F | Human | 1:100-500 | |
| IF | Human | 1:100-500 |
交叉反应
交叉反应: Human
相关产品
暂无相关产品
靶标
Contains 5 Ig-like C2-type (immunoglobulin-like) domains.